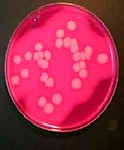
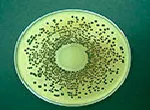

CULTURE MEDIA ADDITIVES
Additives are substances or mixtures that must be incorporated to complete the culture media formulation. They are presented in 100 mL opaque bottles to guarantee the properties are perfectly preserved.

 Rest of the World
Rest of the World